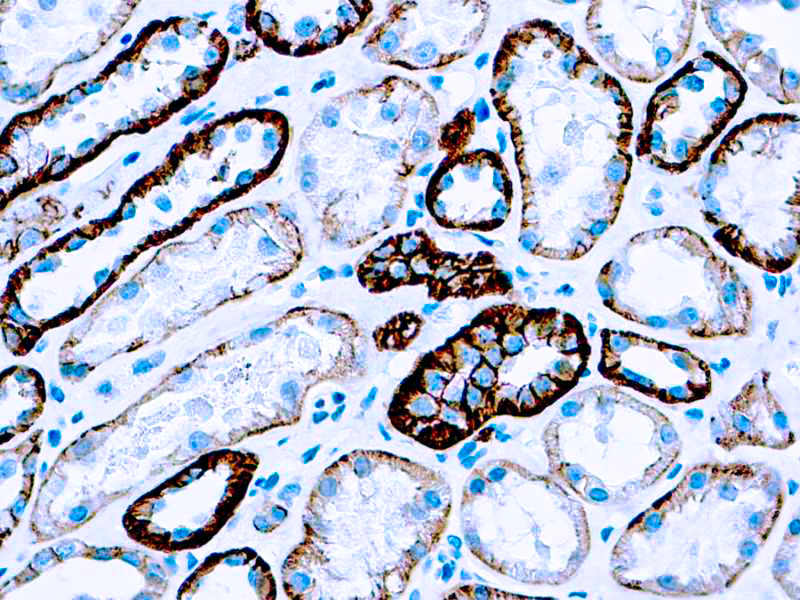

This antibody reacts with pan cadherin with a distinct 135 kDa band from a wide variety of tissues. Cadherins are members of a multigene family of single chain glycoprotein receptors mediating Ca2+ dependent cell-cell adhesion.
Cadherin, Pan
SKU: 8259
Categories: Primary Antibodies, IVD - For U.S. Market, IVD - Outside U.S. Market
Tags: Concentrated, C
Description
Additional information
| Catalog No. | Mob228 Concentrated |
|---|---|
| Clone | CH-19 |
| Isotype | IgG1 |
| Immunogen | Synthetic peptide corresponding to the C-terminal amino acids of chicken N-cadherin with extra N-terminal lysine residue. |
| Species | Mouse |
| Cellular Localization | cell membrane |
| Positive Control Tissue | Tonsil |
| Pretreatment | EDTA (pH 8.0) |
| Incubation & Temperature | 30 min @ RT |
| Intended Use | IVD |
| Detection System | PolyVue Plus – Two Step Detection System or Montage PolyVue Plus Auto Detection System for Montage 360 System |
| Description/Type | Mouse Monoclonal Antibody |
| Format | This product is supplied as an ascites fluid. It contains sodium azide as a preservative. |
DATASHEETS & SDS
DATASHEETS & SDS
| Download Datasheet |
| Download SDS Sheet – OSHA |
REFERENCES
REFERENCES
- Geiger et al. J cell Sciences 97: 607, 1990.
- Grunwald et al. Curr Opin Cell Biol 5: 797, 1993.
Takeichi et al. Development 102: 639, 1988.
Reviews (0)
Only logged in customers who have purchased this product may leave a review.

Reviews
There are no reviews yet.